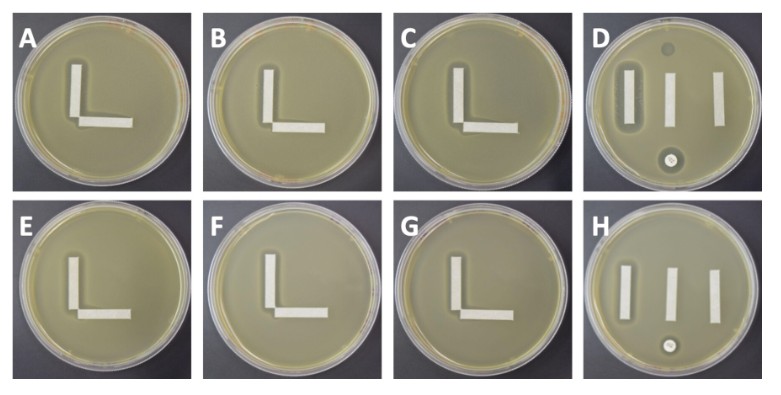

قد يعجبك
Reverse translation!
Good stuff. Sequencing proteins by reverse translating them back into DNA, and then sequencing that.

Phages sometimes work cooperatively with antibiotics to eliminate antibiotic-resistant bacteria. In @JournalSpectrum, researchers describe a simple solid media assay to detect synergy between phages and antibiotics. asm.social/1MN
what a joy to be able to publish a manuscript with one of our undergraduate researchers - Eldana Bedru micropublication.org/journals/biolo…
nature.com
Drug-resistant microbes: ‘brain drain’ is derailing the fight to stop them
Nature - A lack of investment is driving researchers who study antimicrobial resistance out of the field, an industry body warns.
Well-deserved recognition of Val’s remarkable contributions to TB research. Congratulations!
Congratulations to Professor Valerie Mizrahi, Director of @UCTIDM on her election as Fellow of the Royal Society, London, for her substantial contribution to the advancement of science, particularly in the area of tuberculosis in Africa. Read more: news.uct.ac.za/images/userfil…

TOMORROW! @LSHTM_TB Free & Open to all "Experts speak: what People with TB want researchers to know" lshtm.ac.uk/newsevents/eve…
United States الاتجاهات
- 1. $SWC 2,486 posts
- 2. Mateer 4,456 posts
- 3. #UFC321 71.7K posts
- 4. Ole Miss 11.8K posts
- 5. Almeida 53.7K posts
- 6. Volkov 46.1K posts
- 7. Arbuckle 2,407 posts
- 8. Oklahoma 16.6K posts
- 9. Umar 24.9K posts
- 10. Lane Kiffin 5,489 posts
- 11. UCLA 7,777 posts
- 12. Brentford 34.9K posts
- 13. Kerkez 12K posts
- 14. Hugh Freeze 1,323 posts
- 15. Arkansas 19.9K posts
- 16. Jackson Arnold 1,023 posts
- 17. Bautista 44.4K posts
- 18. Memphis 13.6K posts
- 19. Wake Forest 1,531 posts
- 20. #Sooners 2,184 posts
Something went wrong.
Something went wrong.





























































































